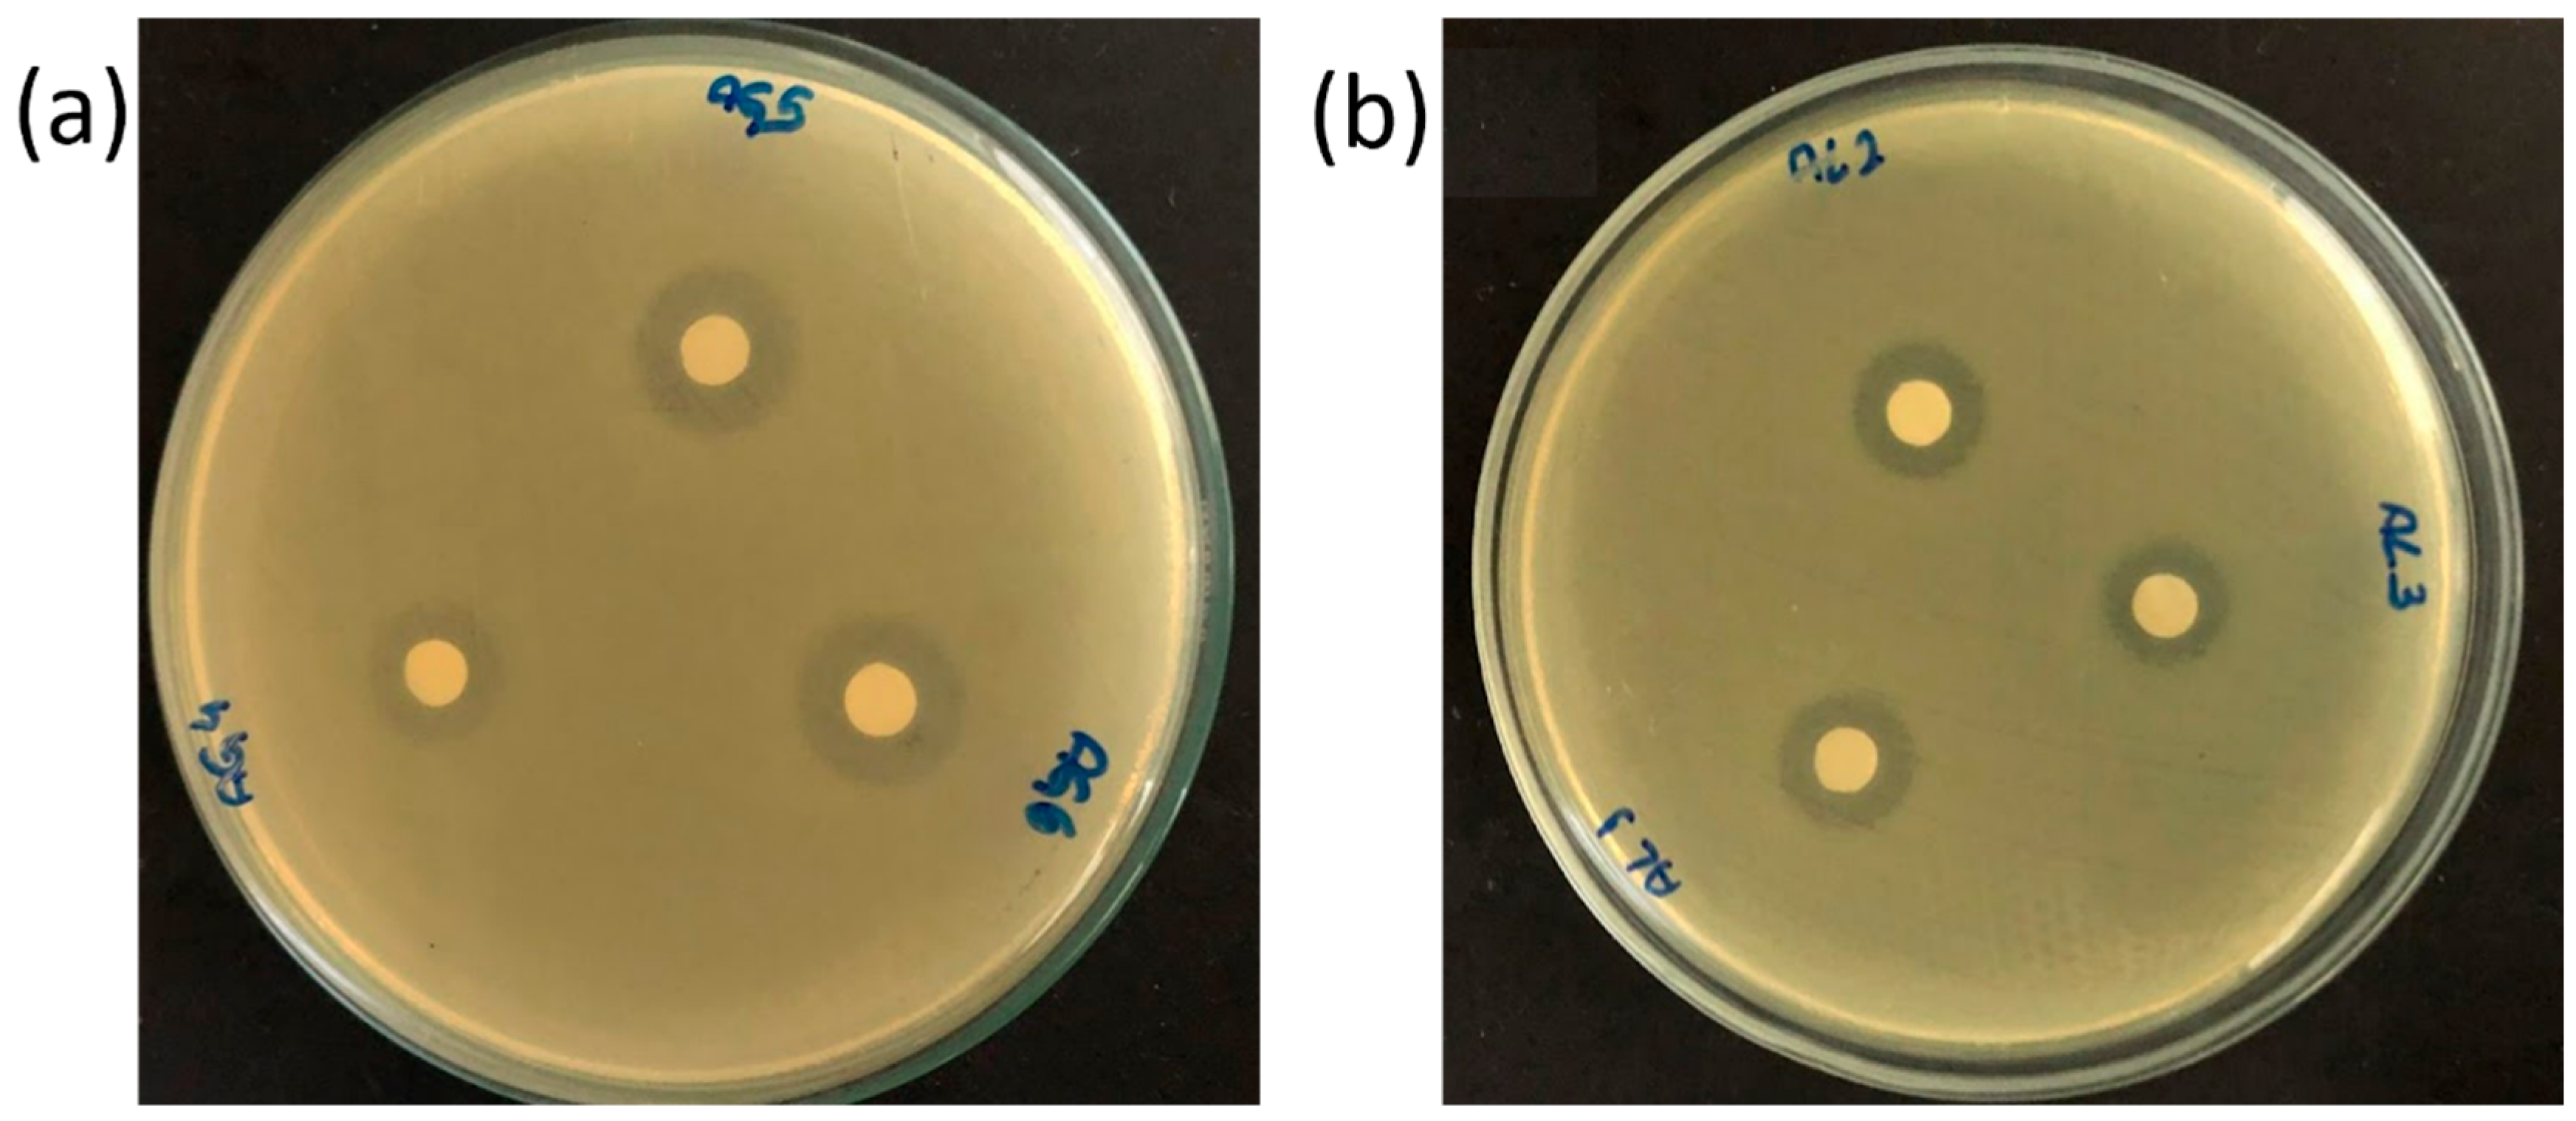
Processes 11 02948 g003

Antibacterial Potential of Activated Carbon Impregnated with Garlic Extract
Abstract
:1. Introduction
2. Materials and Methods
2.1. Materials
2.2. Methods
2.2.1. Garlic Extract
2.2.2. Acid Functionalization of the Babassu-Activated Carbon (BAC)
2.2.3. Impregnation of Garlic Extract in the BAC and NFC Samples
2.2.4. Characterization of the Activated Carbons
2.2.5. Synthetic Hospital Wastewater
2.2.6. Bactericide Analysis
2.2.7. Disk Diffusion Antimicrobial Susceptibility Testing
3. Results and Discussion
3.1. Allicin Concentration in Garlic Extract
3.2. Characterization of the Activated Carbon Samples
3.3. Study of the Impregnation of Allicin in the Activated Carbon Samples
3.4. Microbiological Analysis
4. Conclusions
Author Contributions
Funding
Data Availability Statement
Acknowledgments
Conflicts of Interest
Abbreviations
| Abbreviation | Meaning |
| BAC | Babassu Activated Carbon |
| BACW | Babassu Activated Carbon Impregnated with Water Extract |
| BACE | Babassu Activated Carbon Impregnated with Ethanol Extract |
| NFC | Nitric Functionalized Carbon |
| NFCW | Nitric Functionalized Carbon Impregnated with Water Extract |
| NFCE | Nitric Functionalized Carbon Impregnated with Ethanol Extract |
| COD | Chemical Oxygen Demand |
| FTIR | Fourier-Transform Infrared Spectroscopy |
| HWW | Hospital Wastewater |
| PZC | Point of Zero Charge |
| SEM | Scanning Electron Microscopy |
| SBET | Superficial Area According to BET Model |
| Vp | Total Volume of the Activated Carbon |
| dp | Average Pore Diameter of the Activated Carbon |
References
- Kumari, A.; Maurya, N.S.; Tiwari, B. Hospital Wastewater Treatment Scenario around the Globe. In Current Developments in Biotechnology and Bioengineering; Elsevier: Amsterdam, The Netherlands, 2020; pp. 549–570. [Google Scholar]
- Lutterbeck, C.A.; Colares, G.S.; Oliveira, G.A.; Mohr, G.; Beckenkamp, F.; Rieger, A.; Lobo, E.A.; Rodrigues, L.H.R.; Machado, Ê.L. Microbial Fuel Cells and Constructed Wetlands as a Sustainable Alternative for the Treatment of Hospital Laundry Wastewaters: Assessment of Load Parameters and Genotoxicity. J. Environ. Chem. Eng. 2022, 10, 108105. [Google Scholar] [CrossRef]
- Khan, N.A.; Ullah Khan, S.; Ahmed, S.; Farooqi, I.H.; Hussain, A.; Vambol, S.; Vambol, V. Smart Ways of Hospital Wastewater Management, Regulatory Standards and Conventional Treatment Techniques. Smart Sustain. Built Environ. 2019, 9, 727–736. [Google Scholar] [CrossRef]
- Lutterbeck, C.A.; Colares, G.S.; Dell’Osbel, N.; da Silva, F.P.; Kist, L.T.; Machado, Ê.L. Hospital Laundry Wastewaters: A Review on Treatment Alternatives, Life Cycle Assessment and Prognosis Scenarios. J. Clean. Prod. 2020, 273, 122851. [Google Scholar] [CrossRef]
- Chonova, T.; Keck, F.; Labanowski, J.; Montuelle, B.; Rimet, F.; Bouchez, A. Separate Treatment of Hospital and Urban Wastewaters: A Real Scale Comparison of Effluents and Their Effect on Microbial Communities. Sci. Total Environ. 2016, 542, 965–975. [Google Scholar] [CrossRef]
- Rehman, H. Analysis of Physicochemical Parameters of Hospitals Wastewater: A Case Study in Faisalabad, Pakistan. Pure Appl. Biol. 2020, 9, 1191–1198. [Google Scholar] [CrossRef]
- Majumder, A.; Gupta, A.K.; Ghosal, P.S.; Varma, M. A Review on Hospital Wastewater Treatment: A Special Emphasis on Occurrence and Removal of Pharmaceutically Active Compounds, Resistant Microorganisms, and SARS-CoV-2. J. Environ. Chem. Eng. 2021, 9, 104812. [Google Scholar] [CrossRef]
- Sharma, M.; Yadav, A.; Dubey, K.K.; Tipple, J.; Das, D.B. Decentralized Systems for the Treatment of Antimicrobial Compounds Released from Hospital Aquatic Wastes. Sci. Total Environ. 2022, 840, 156569. [Google Scholar] [CrossRef]
- Mcdonald, T.A.; Komulainen, H. Carcinogenicity of the Chlorination Disinfection by-Product MX. J. Environ. Sci. Health Part C 2005, 23, 163–214. [Google Scholar] [CrossRef]
- Wang, H.; Zhu, Y.; Hu, C.; Hu, X. Treatment of NOM Fractions of Reservoir Sediments: Effect of UV and Chlorination on Formation of DBPs. Sep. Purif. Technol. 2015, 154, 228–235. [Google Scholar] [CrossRef]
- Rosińska, A.; Rakocz, K. The Influence UV/Chlorination Process on Changes of Biodegradable Fraction in Water. J. Clean. Prod. 2021, 278, 123947. [Google Scholar] [CrossRef]
- El-Saber Batiha, G.; Beshbishy, A.M.; Wasef, L.; Elewa, Y.H.A.; Al-Sagan, A.A.; El-Hack, M.E.A.; Taha, A.E.; Abd-Elhakim, Y.M.; Devkota, H.P. Chemical Constituents and Pharmacological Activities of Garlic (Allium sativum L.): A Review. Nutrients 2020, 12, 872. [Google Scholar] [CrossRef] [PubMed]
- Wang, H.; Li, X.; Liu, X.; Shen, D.; Qiu, Y.; Zhang, X.; Song, J. Influence of PH, Concentration and Light on Stability of Allicin in Garlic (Allium sativum L.) Aqueous Extract as Measured by UPLC. J. Sci. Food Agric. 2015, 95, 1838–1844. [Google Scholar] [CrossRef] [PubMed]
- dos Santos, D.F.; Moreira, W.M.; de Araújo, T.P.; Bergamasco, R.; Ostroski, I.C.; de Barros, M.A.S.D. Non-Conventional Processes Applied for the Removal of Pharmaceutics Compounds in Waters: A Review. Process Saf. Environ. Prot. 2022, 167, 527–542. [Google Scholar] [CrossRef]
- Ajala, O.J.; Tijani, J.O.; Salau, R.B.; Abdulkareem, A.S.; Aremu, O.S. A Review of Emerging Micro-Pollutants in Hospital Wastewater: Environmental Fate and Remediation Options. Results Eng. 2022, 16, 100671. [Google Scholar] [CrossRef]
- Arevalo-Fester, J. Efficiency Study of Silver Nanoparticles (AgNPs) Supported on Granular Activated Carbon against Escherichia coli. J. Nanomed. Res. 2014, 1, 00009. [Google Scholar] [CrossRef]
- Burchacka, E.; Pstrowska, K.; Beran, E.; Fałtynowicz, H.; Chojnacka, K.; Kułażyński, M. Antibacterial Agents Adsorbed on Active Carbon: A New Approach for S. Aureus and E. coli Pathogen Elimination. Pathogens 2021, 10, 1066. [Google Scholar] [CrossRef] [PubMed]
- Natori, Y.; Kinase, Y.; Ikemoto, N.; Spaziani, F.; Kojima, T.; Kakuta, H.; Fujita, J.; Someya, K.; Tatenuma, K.; Yabuta, T.; et al. Activated Carbon Impregnated with Elementary Iodine: Applications against Virus- and Bacteria-Related Issues. C 2021, 7, 86. [Google Scholar] [CrossRef]
- Li, Y.; Deletic, A.; Henry, R.; Zhang, T.H.; McCarthy, D.T. Copper(II) Hydroxide/Oxide-Coated Granular Activated Carbon for E. coli Removal in Water. Blue-Green Syst. 2022, 4, 310–325. [Google Scholar] [CrossRef]
- Suresh, R.; Rajendran, S. Carbon-Based Adsorbents for Remediation of Noxious Pollutants from Water and Wastewater. In Sustainable Materials for Sensing and Remediation of Noxious Pollutants; Elsevier: Amsterdam, The Netherlands, 2022; pp. 177–194. [Google Scholar]
- Bhatwalkar, S.B.; Mondal, R.; Krishna, S.B.N.; Adam, J.K.; Govender, P.; Anupam, R. Antibacterial Properties of Organosulfur Compounds of Garlic (Allium sativum). Front. Microbiol. 2021, 12, 613077. [Google Scholar] [CrossRef]
- González, N.G.; Larrégola, S.; Pereira, F.; Cadus, L.E.; Morales, M.R. Surface Acid Functionalization of Activated Carbons and Its Influence on the Copper-Support Interactions. In Proceedings of the ECCS 2021, Vienna, Austria, 13–15 July 2021; p. 6. [Google Scholar]
- Jun, L.Y.; Mubarak, N.M.; Yon, L.S.; Bing, C.H.; Khalid, M.; Abdullah, E.C. Comparative Study of Acid Functionalization of Carbon Nanotube via Ultrasonic and Reflux Mechanism. J. Environ. Chem. Eng. 2018, 6, 5889–5896. [Google Scholar] [CrossRef]
- Kim, J.-H.; Hwang, S.Y.; Park, J.E.; Lee, G.B.; Kim, H.; Kim, S.; Hong, B.U. Impact of the Oxygen Functional Group of Nitric Acid-Treated Activated Carbon on KOH Activation Reaction. Carbon Lett. 2019, 29, 281–287. [Google Scholar] [CrossRef]
- Baby, R.; Hussein, M.; Zainal, Z.; Abdullah, A. Functionalized Activated Carbon Derived from Palm Kernel Shells for the Treatment of Simulated Heavy Metal-Contaminated Water. Nanomaterials 2021, 11, 3133. [Google Scholar] [CrossRef] [PubMed]
- Yamaguchi, Y.; Kumagai, H. Characteristics, Biosynthesis, Decomposition, Metabolism and Functions of the Garlic Odour Precursor, S-allyl-l-cysteine Sulfoxide (Review). Exp. Ther. Med. 2019, 19, 1528–1535. [Google Scholar] [CrossRef]
- Irkin, R.; Korukluoglu, M. Control of Aspergillus Niger with Garlic, Onion and Leek Extracts. Afr. J. Biotechnol. 2007, 6, 384–387. [Google Scholar]
- Borlinghaus, J.; Foerster (née Reiter), J.; Kappler, U.; Antelmann, H.; Noll, U.; Gruhlke, M.; Slusarenko, A. Allicin, the Odor of Freshly Crushed Garlic: A Review of Recent Progress in Understanding Allicin’s Effects on Cells. Molecules 2021, 26, 1505. [Google Scholar] [CrossRef] [PubMed]
- Schwimmer, S.; Weston, W.J. Onion Flavor and Odor, Enzymatic Development of Pyruvic Acid in Onion as a Measure of Pungency. J. Agric. Food Chem. 1961, 9, 301–304. [Google Scholar] [CrossRef]
- Dethier, B.; Nott, K.; Fauconnier, M.L. (Bio)Synthesis, Extraction and Purification of Garlic Derivatives Showing Therapeutic Properties. Commun. Agric. Appl. Biol. Sci. 2013, 78, 149–155. [Google Scholar]
- Smičiklas, I.; Milonjić, S.; Pfendt, P.; Raičević, S. The Point of Zero Charge and Sorption of Cadmium (II) and Strontium (II) Ions on Synthetic Hydroxyapatite. Sep. Purif. Technol. 2000, 18, 185–194. [Google Scholar] [CrossRef]
- Boehm, H.P. Chemical Identification of Surface Groups. In Advances in Catalysis; Academic Press: Cambridge, MA, USA, 1966; pp. 179–274. [Google Scholar]
- Hoppen, M.I.; Carvalho, K.Q.; Ferreira, R.C.; Passig, F.H.; Pereira, I.C.; Rizzo-Domingues, R.C.P.; Lenzi, M.K.; Bottini, R.C.R. Adsorption and Desorption of Acetylsalicylic Acid onto Activated Carbon of Babassu Coconut Mesocarp. J. Environ. Chem. Eng. 2019, 7, 102862. [Google Scholar] [CrossRef]
- Julien, F.; Baudu, M.; Mazet, M. Relationship between Chemical and Physical Surface Properties of Activated Carbon. Water Res. 1998, 32, 3414–3424. [Google Scholar] [CrossRef]
- Schönherr, J.; Buchheim, J.R.; Scholz, P.; Adelhelm, P. Boehm Titration Revisited (Part II): A Comparison of Boehm Titration with Other Analytical Techniques on the Quantification of Oxygen-Containing Surface Groups for a Variety of Carbon Materials. C 2018, 4, 22. [Google Scholar] [CrossRef]
- Tiwari, B.; Sellamuthu, B.; Piché-Choquette, S.; Drogui, P.; Tyagi, R.D.; Vaudreuil, M.A.; Sauvé, S.; Buelna, G.; Dubé, R. The Bacterial Community Structure of Submerged Membrane Bioreactor Treating Synthetic Hospital Wastewater. Bioresour. Technol. 2019, 286, 121362. [Google Scholar] [CrossRef] [PubMed]
- Parashar, V.; Singh, S.; Purohit, M.R.; Tamhankar, A.J.; Singh, D.; Kalyanasundaram, M.; Lundborg, C.S.; Diwan, V. Utility of Constructed Wetlands for Treatment of Hospital Effluent and Antibiotic Resistant Bacteria in Resource Limited Settings: A Case Study in Ujjain, India. Water Environ. Res. 2022, 94, e10783. [Google Scholar] [CrossRef]
- Matuschek, E.; Brown, D.F.J.; Kahlmeter, G. Development of the EUCAST Disk Diffusion Antimicrobial Susceptibility Testing Method and Its Implementation in Routine Microbiology Laboratories. Clin. Microbiol. Infect. 2014, 20, O255–O266. [Google Scholar] [CrossRef] [PubMed]
- Rodriguez-Clemente, E.; Gonzalez-Rodriguez, J.G.; Valladarez-Cisneros, M.G.; Chacon-Nava, J.G.; Flores-De los Ríos, J.P.; Rodriguez-Valdez, L.M. Experimental and Theoretical Evaluation of Allicin as Corrosion Inhibitor for Carbon Steel in Sulfuric Acid. J. Mater. Environ. Sci. 2017, 8, 2028–2508. [Google Scholar]
- Kemp, D.D.; Gordon, M.S. An Interpretation of the Enhancement of the Water Dipole Moment Due to the Presence of Other Water Molecules. J. Phys. Chem. A 2008, 112, 4885–4894. [Google Scholar] [CrossRef]
- Martín, M.E.; Sánchez, M.L.; Olivares del Valle, F.J.; Aguilar, M.A. A Theoretical Study of Liquid Alcohols Using Averaged Solvent Electrostatic Potentials Obtained from Molecular Dynamics Simulations: Methanol, Ethanol and Propanol. J. Chem. Phys. 2002, 116, 1613–1620. [Google Scholar] [CrossRef]
- Ferreira, R.C.; de Lima, H.H.C.; Cândido, A.A.; Junior, O.M.C.; Arroyo, P.A.; Gauze, G.F.; Carvalho, K.Q.; Barros, M.A.S.D. Adsorption of Paracetamol Using Activated Carbon of Dende and Babassu Coconut Mesocarp. Int. J. Biol. Biomol. Agric. Food Biotechnol. Eng. 2015, 9, 575–580. [Google Scholar]
- Ternero-Hidalgo, J.J.; Rosas, J.M.; Palomo, J.; Valero-Romero, M.J.; Rodríguez-Mirasol, J.; Cordero, T. Functionalization of Activated Carbons by HNO3 Treatment: Influence of Phosphorus Surface Groups. Carbon 2016, 101, 409–419. [Google Scholar] [CrossRef]
- de Fatima Salgado, M.; da Silva Trindade, N.D.; dos Santos Silva, J.; Viana, V.G.; Abioye, A.M.; Ani, F.N. Activated Carbon from Brazilian Babassu Nutshell Using Physical Route and Microwave Radiation. In Proceedings of the International Seminar of Science and Applied Technology (ISSAT 2020); Atlantis Press: Paris, France, 2020. [Google Scholar]
- Wan, Z.; Li, K. Effect of Pre-Pyrolysis Mode on Simultaneous Introduction of Nitrogen/Oxygen-Containing Functional Groups into the Structure of Bagasse-Based Mesoporous Carbon and Its Influence on Cu(II) Adsorption. Chemosphere 2018, 194, 370–380. [Google Scholar] [CrossRef]
- Su, P.; Zhang, J.; Tang, J.; Zhang, C. Preparation of Nitric Acid Modified Powder Activated Carbon to Remove Trace Amount of Ni(II) in Aqueous Solution. Water Sci. Technol. 2019, 80, 86–97. [Google Scholar] [CrossRef] [PubMed]
- Soudani, N.; Souissi-najar, S.; Ouederni, A. Influence of Nitric Acid Concentration on Characteristics of Olive Stone Based Activated Carbon. Chin. J. Chem. Eng. 2013, 21, 1425–1430. [Google Scholar] [CrossRef]
- Moreira, M.R.; Ponce, A.; del Valle, C.E.; Roura, S.I. Inhibitory Parameters of Essential Oils to Reduce a Foodborne Pathogen. LWT-Food Sci. Technol. 2005, 38, 565–570. [Google Scholar] [CrossRef]
- López, P.; Sánchez, C.; Batlle, R.; Nerín, C. Vapor-Phase Activities of Cinnamon, Thyme, and Oregano Essential Oils and Key Constituents against Foodborne Microorganisms. J. Agric. Food Chem. 2007, 55, 4348–4356. [Google Scholar] [CrossRef] [PubMed]
- Mith, H.; Duré, R.; Delcenserie, V.; Zhiri, A.; Daube, G.; Clinquart, A. Antimicrobial Activities of Commercial Essential Oils and Their Components against Food-borne Pathogens and Food Spoilage Bacteria. Food Sci. Nutr. 2014, 2, 403–416. [Google Scholar] [CrossRef]
- Hocquet, D.; Muller, A.; Bertrand, X. What Happens in Hospitals Does Not Stay in Hospitals: Antibiotic-Resistant Bacteria in Hospital Wastewater Systems. J. Hosp. Infect. 2016, 93, 395–402. [Google Scholar] [CrossRef]
- Rozman, U.; Duh, D.; Cimerman, M.; Turk, S.Š. Hospital Wastewater Effluent: Hot Spot for Antibiotic Resistant Bacteria. J. Water Sanit. Hyg. Dev. 2020, 10, 171–178. [Google Scholar] [CrossRef]
- Salehi, B.; Zucca, P.; Orhan, I.E.; Azzini, E.; Adetunji, C.O.; Mohammed, S.A.; Banerjee, S.K.; Sharopov, F.; Rigano, D.; Sharifi-Rad, J.; et al. Allicin and Health: A Comprehensive Review. Trends Food Sci. Technol. 2019, 86, 502–516. [Google Scholar] [CrossRef]
- Ankri, S.; Mirelman, D. Antimicrobial Properties of Allicin from Garlic. Microbes Infect. 1999, 1, 125–129. [Google Scholar] [CrossRef]
- Amala, S.E.; Nweke, S.N.; Nwalozie, R.; Monsi, T.P. Antimicrobial Properties and Phytochemical Composition of Garcinia kola, Bryophyllum pinnatum, and Allium sativum Juices on Some Clinical Pathogens. Adv. Biosci. Biotechnol. 2021, 12, 388–406. [Google Scholar] [CrossRef]
- Hussain, M.S.; Ghafoor, M.B.; Cheema, U.K.; Sajjad, M.; Akhtar, M.S. Antibacterial Effect of Allium Cepa (Onion), Allium sativum (Garlic), Azadirachta Indica (Neem) Extract against Different Bacteria Isolated from Clinical Sample. Prof. Med. J. 2021, 28, 1083–1089. [Google Scholar] [CrossRef]
- Li, S.; Yan, X.; Yang, Z.; Yang, Y.; Liu, X.; Zou, J. Preparation and Antibacterial Property of Silver Decorated Carbon Microspheres. Appl. Surf. Sci. 2014, 292, 480–487. [Google Scholar] [CrossRef]
- Lukasik, J.; Cheng, Y.-F.; Lu, F.; Tamplin, M.; Farrah, S.R. Removal of Microorganisms from Water by Columns Containing Sand Coated with Ferric and Aluminum Hydroxides. Water Res. 1999, 33, 769–777. [Google Scholar] [CrossRef]
- Mohanty, S.K.; Torkelson, A.A.; Dodd, H.; Nelson, K.L.; Boehm, A.B. Engineering Solutions to Improve the Removal of Fecal Indicator Bacteria by Bioinfiltration Systems during Intermittent Flow of Stormwater. Environ. Sci. Technol. 2013, 47, 10791–10798. [Google Scholar] [CrossRef] [PubMed]

| Compound | Concentration (mg L−1) |
|---|---|
| Na2CO3 | 428.60 |
| CaCl2·2H2O | 22.10 |
| ZnCl2 | 0.23 |
| FeCl3 | 11.63 |
| KH2PO4 | 92.19 |
| C6H12O6 | 938.35 |
| Na2MoO4·2H2O | 0.10 |
| (NH4)2SO4 | 353.57 |
| CuSO4 | 0.07 |
| MnSO4·H2O | 0.12 |
| CoSO4·7H2O | 0.48 |
| MgSO4 | 34.68 |
| Samples | SBET (m2 g−1) | Vp (cm3 g−1) | dp (nm) |
|---|---|---|---|
| BAC | 586.08 | 0.3365 | 2.30 |
| NFC | 543.92 | 0.3107 | 2.29 |
| NFCW | 225.60 | 0.1333 | 2.36 |
| NFCE | 427.30 | 0.2457 | 2.30 |
| Boehm Titration | BAC | NFC | |
|---|---|---|---|
| Acid groups (meq g−1) | Carboxylic | 0.05 ± 0.01 | --- |
| Lactonic | 0.15 ± 0.10 | 0.30 ± 0.06 | |
| Phenolic | 0.35 ± 0.04 | 0.40 ± 0.01 | |
| Basic groups (meq g−1) | 0.10 ± 0.03 | --- | |
| PZC | 6.86 ± 0.00 | 3.07 ± 0.00 | |
| Impregnated Sample | Estimated Amount of Allicin (µmol g−1) | % Releasing Allicin |
|---|---|---|
| BACW | 0.553 | ~100% |
| BACE | 0.465 | ~100% |
| NFCW | 0.408 | <20% |
| NFCE | 0.300 | <20% |
| Sample | Raw Effluent (0.1 µL) | Post-Treatment (Mean ± sd) (Colonies) | Efficiency (%) |
|---|---|---|---|
| BAC | >200 | >200 | 0.0% |
| NFC | >200 | >200 | 0.0% |
| NFCW | >200 | 0 ± 0.67 | 100% |
| NFCE | >200 | 1 ± 0.51 | 99.5% |
| Support | Impregnated Agent | Inhibition of E. coli Growth | Reference |
|---|---|---|---|
| Pharmaceutical activated carbon | None | 20.5 to 26.5% | [17] |
| Pharmaceutical activated carbon | Sulfamethoxazole | 47 to 72% | [17] |
| Activated carbon | Molecular iodine (I2) | 4.0 log E coli reduction | [18] |
| Activated carbon | Copper(II) hydroxide nanoparticles | 3.0 to 1.6 log reduction | [19] |
| Sand | Iron Oxide | 98 to 99% | [59] |
| Sand | Ferric and aluminum hydroxide | >99% | [58] |
| Acid-treated Activated Carbon | Allicin alcoholic solution | 99.5%—5 log reduction | This Work. |
| Acid-treated Activated Carbon | Allicin aqueous solution | 100%—5 log reduction | This Work. |
Disclaimer/Publisher’s Note: The statements, opinions and data contained in all publications are solely those of the individual author(s) and contributor(s) and not of MDPI and/or the editor(s). MDPI and/or the editor(s) disclaim responsibility for any injury to people or property resulting from any ideas, methods, instructions or products referred to in the content. |
© 2023 by the authors. Licensee MDPI, Basel, Switzerland. This article is an open access article distributed under the terms and conditions of the Creative Commons Attribution (CC BY) license (https://creativecommons.org/licenses/by/4.0/).
Share and Cite
Alvarino, L.A.d.S.; Manzotti, F.; Moreira, W.M.; de Araújo, T.P.; Vareschini, D.T.; de Barros, M.A.S.D. Antibacterial Potential of Activated Carbon Impregnated with Garlic Extract. Processes 2023, 11, 2948. https://doi.org/10.3390/pr11102948
Alvarino LAdS, Manzotti F, Moreira WM, de Araújo TP, Vareschini DT, de Barros MASD. Antibacterial Potential of Activated Carbon Impregnated with Garlic Extract. Processes. 2023; 11(10):2948. https://doi.org/10.3390/pr11102948
Chicago/Turabian StyleAlvarino, Lauro Adeilson da Silva, Fernando Manzotti, Wardleison Martins Moreira, Thiago Peixoto de Araújo, Daniel Tait Vareschini, and Maria Angélica Simões Dornellas de Barros. 2023. "Antibacterial Potential of Activated Carbon Impregnated with Garlic Extract" Processes 11, no. 10: 2948. https://doi.org/10.3390/pr11102948
APA StyleAlvarino, L. A. d. S., Manzotti, F., Moreira, W. M., de Araújo, T. P., Vareschini, D. T., & de Barros, M. A. S. D. (2023). Antibacterial Potential of Activated Carbon Impregnated with Garlic Extract. Processes, 11(10), 2948. https://doi.org/10.3390/pr11102948








